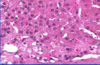

Adrenal Flashcards
(117 cards)
what part of the adrenal?

Largest zone is fasciculata and consists of large polygonal cells with prominent cytoplasmic borders. They are clear back heels which contain lipid, and when adrenal is functional and the lipid is depleted, the cells look more granular or eosinophilic.
What condition has cortical atrophy?
exogenous cushing
bromocriptine
dopaminergic agonist
high dose dexamethasone suppression test
cushing’s disease - where is it coming from?
higher dose of dexamethasone will decrease cortisol secretion in normal and patients with pituitary ACTH excess (cushin’g disease) but not in ectopic/adrenal ACTH cushing’s syndrome (there is much more acth in ectopic

what receptors do epi/NE bind?
- Epi and NE can either bind to either alpha-receptors or beta-receptors. There are several subtypes of each receptor.
- The important thing I want you to remember: The effect will depend on which receptor gets bound.
- Don’t memorize all this. Just realize the theme of hormone activity.
- Think of epinephrine as a hormone, whose activity depends on which receptor it binds.
- You can have totally opposite effects depending on the receptor.

Conn syndrome
aldosterone producing adenoma - primary hyperaldosteronism
indistinguishable from other adenomas
small yellow circumscribed nodule, indstinguishable from others
cells mostly resemble fasiculata or mixed

chronic treatment of adrenal insufficiency
glucocorticoid/mineralocorticoid/androgen replacement
acute primary adrenal insufficiency
crisis in chronic insufficiency, withdrawl of corticosteroids (need to taper!!), DIC/post surgical/waterhouse-friederchsen
secondary adrenal insufficiency
pituitary/hypothalamic disorder that reduces ACTH –> decrease cortisol and androgens (similar to Addison’s disease)
diff: no hyperpigmentation (suppressed ACTH), normal aldo levels (not dep on ACTH)
cushing’s syndrome
syndrome of excess cortison from any cause
meds
cushing’s disease (pituitary tumor secreting ACTH)
ectopic ACTH secreting turmor
adrenal tumor (benign or malignant)
octreotide
somatostatin analog
waterhouse-friderichsen syndrome
crisis of acute adrenal insufficiency
overwhelming bacterial infection
DIC and rapid hypotension
massive adrenal hemorrhage and adrenocrotical insufficiency
Bacterial infection usually caused by meningitides bacteria
Because of all of that, they have massive adrenal hemorrhage and thus insufficiency.
What is the trigger for catecholamine release?
Acetylcholine
epinephrine and NE release

malignant pheochromocytoma
The only way we can know for sure if it’s malignant is if it’s metastasized. Otherwise they can show a lot of pleomorphism – see how big and dark these nuclei are. That’s not a helpful feature in endocrine organs as opposed to epithelial organs, where we expect cancer if we see this.
They can also have mitosis and vascular invasion and can even be found outside of adrenal (extra-adrenal paragangliomas).
You really have to prove metastasis to prove it’s malignant. In real life we try to apply several features including invasion of other organs, of vessels, if too many mitosis we may comment that the tumor has a higher malignant potential.

MSH
cross reacts with ACTH
causes pigment formation
Addison’s
secondary/tertiary adrenal insufficiency
low ACTH
may be associated with other pituitary defects
i.e. long term steroids, pituitary tumor, genetic, ACTH deficiency
cortisol on GFR
- GFR: Cortisol is also required for normal GFR.
- Excess cortisol à increases the GFR
- When the prof’s dog, India, was on prednisone, she had to be taken out to peeing much more often. The dog also had diabetes insipidus.. So you can imagine.
- Diabetes insipidus is a lack of vasopressin activity, which results in dilute urine. For diagnosis, test for specific gravity of the urine.
- Prof’s dog had a very low urinary specific gravity. The dog was not given water for overnight, but the specific gravity did not change. The dog was then given DDAVP, which raised the specific gravity. This confirmed that the dog lacked vasopressin.
what disorder is ACTH the highest?
ectopic ACTH
ACTH-dependent Cushing’s Syndrome
High ACTH
- Cushing’s Disease (pituitary tumor) - most common
- ectomic ACTH (carcinoid tumor)
Rare: ectopic CRH secretion

cromaffin cells
in adrenal medulla
neuroendocrine granules with epinephrine and NE
granular appearance

primary glucocorticoid deficiency
Addison’s disease - destricution of the adrenal (infection, autoimmunity, trauma)
high ACTH - can cause darkening of the skin due to crossreaction with receptors for MSH (skin pigment formation)
melanogenic agent
ACTH
associated with hyperpigmentation
hypercortisolism
cushing’s syndrome - exogenous or endogenous
cushing disease - pituitary adenoma - high ACTH
adrenal cushing syndrome - hyperplasia/adenoma of adrenal - independent of ACTH
ectopic cushing - neoplasm producing ectopic ACTH
On the left, there’s elevated ACTH, either because of pituitary tumor or ectopic paraneoplastic production (such as tumors in lungs or other neuroendocrine tumors). The high ACTH works bilaterally, so the adrenals are hyperplastic and enlarged.
IF exogenous cause (meds), these are gonna suppress ACTH which means that adrenals are atrophic! These patients we don’t stop cortisol suddenly because the cortex won’t function properly without transition.
IF we have tumor in adrenal that produces cortisol, it too will suppress ACTH which will also cause bilateral atrophy of cortex.
Some causes are caused by idiopathic hyperplasia where there’s suppressed ACTH but maybe something affects the ACTH receptors and stimulates them.

cortisol binding protein
- Glucocorticoids are secreted; they are ~90% bound to a serum-binding protein—cortisol binding globulins (CBG).
- CBG is similar to TBG in terms of its physiology and biochemistry.
- It is the free form of cortisol that is active.
- CBG-bound forms are inactive.
- Like TBG, CBG levels can change depending on factors such as the liver disease.
- Free cortisol is able to diffuse into the cell, bind to a receptor within the cytosol (usually paired w/ heat shock protein or chaperone protein, which can dissociate after receptor-hormone binding).